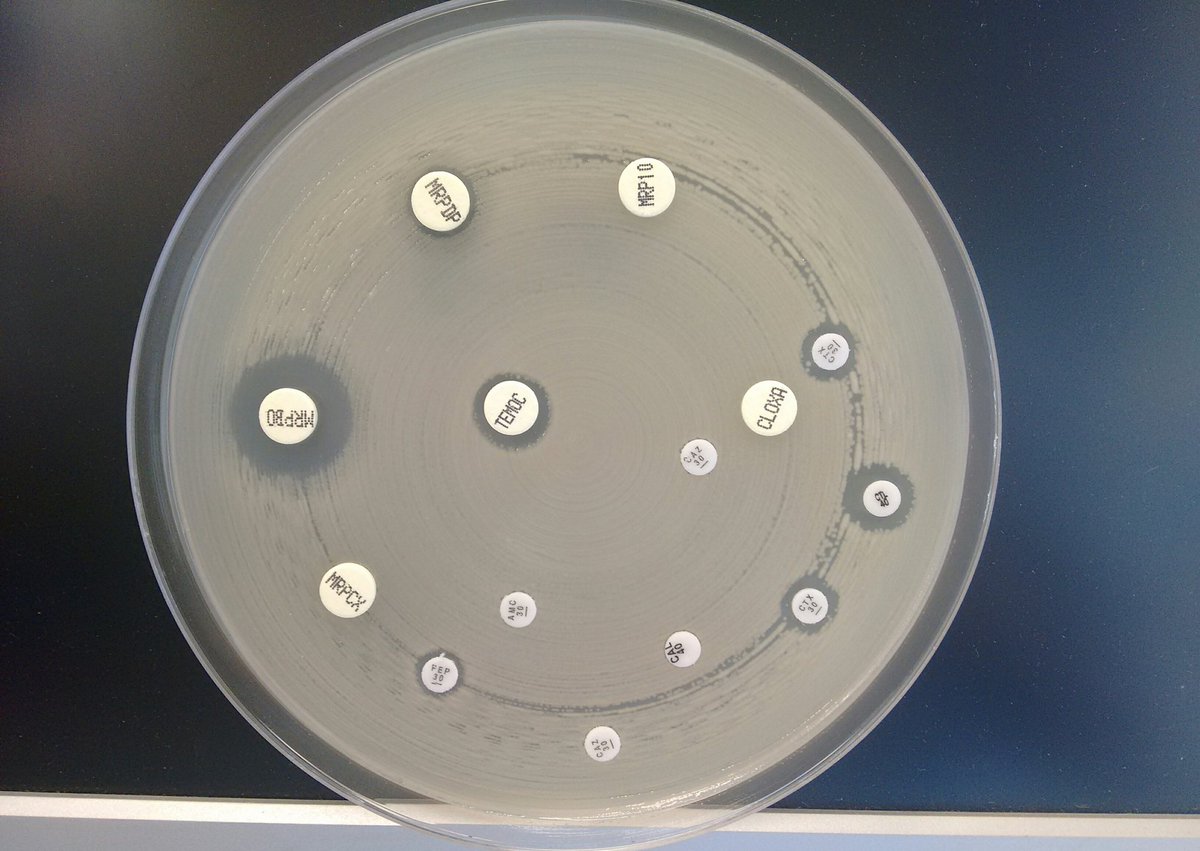
Ángel Rodríguez-Villodres tweet media

Sabitlenmiş Tweet

I'm Ángel, I'm studying about virulence factors and antibiotic resistance in bacterial pathogens. #actuallivingscientist

English
Ángel Rodríguez-Villodres
11K posts

@1797Angel
Clinical microbiologist working on the resistance...to the antibiotics at the University Hospital Virgen del Rocío

Happy to share that 13 projects involving 64 partners from 15 different countries have been recommended for funding within the JPIAMR 17th transnational call! Total requested funding amount is 17,2 M€. More information here: jpiamr.eu/new-projects-i… #WAAW2024 #EAAD2024

